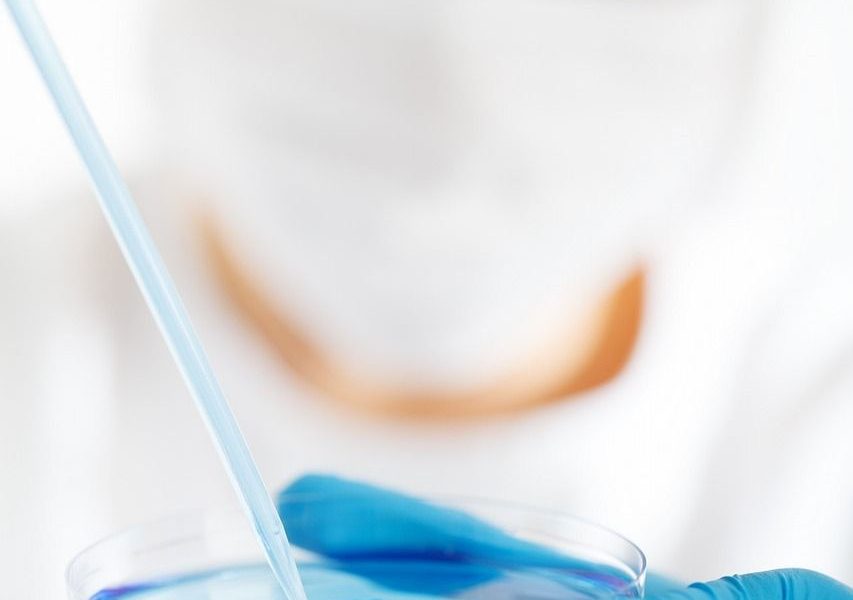

Vad är pfas och varför talar alla om de eviga kemikalierna?

Per- och polyfluorerade alkylsubstanser, mer kända som Pfas, har gått från att vara ett okänt begrepp till att bli en central miljö- och hälsoproblemfråga. De finns i brandskum, stekpannor, funktionskläder, smink, matförpackningar och till och med i dricksvatten. Samtidigt bryts de nästan inte ner i naturen. Den här kombinationen bred användning och extrem stabilitet gör PFAS till en av vår tids mest svårhanterliga kemikaliegrupper.
För den som ansvarar för en anläggning, en verksamhet eller en fastighet väcker PFAS många frågor. Hur stora är riskerna? Hur vet man om marken eller vattnet är påverkat? Och vilka åtgärder krävs för att leva upp till dagens och morgondagens krav?
Pfas egenskaper, hälsorisker och spridningsvägar
PFAS är en stor grupp syntetiska ämnen, ofta kallade evighetskemikalier. De har en kolkedja där väteatomer ersatts av fluor. Den kemiska bindningen mellan kol och fluor är mycket stark, vilket gör att ämnena är extremt svårnedbrytbara.
En enkel definition är:
PFAS är en grupp konstgjorda kemikalier som används för att göra material fett-, smuts- och vattenavvisande. De bryts nästan inte ner i naturen och kan därför byggas upp i både miljö och kropp över lång tid.
Just den här stabiliteten har varit en fördel i industrin. PFAS har använts i allt från brandsläckning till elektronik och textilier, eftersom de tål värme, kemikalier och hård hantering. Men samma stabilitet innebär också att ämnena kan spridas långt och stanna kvar länge.
Några centrala hälsorisker som ofta lyfts fram i forskningen är:
– påverkan på immunförsvaret
– störningar i hormonsystemet
– förhöjda kolesterolnivåer
– möjlig ökad risk för vissa cancerformer
– påverkan på lever och njurar
PFAS kan ta sig in i kroppen via dricksvatten, mat, damm inomhus eller direkt hudkontakt med förorenade produkter. När de väl finns i blodet tar det lång tid innan halterna minskar. I miljön sprids ämnena från punktkällor som brandövningsplatser, industrier eller deponier, vidare ut i grundvatten, ytvatten och mark.
Kort sagt: det som en gång hamnat i mark eller vatten tenderar att stanna kvar och röra sig långsamt men ihållande genom landskapet.

Lagkrav, riktvärden och ansvar vad förväntas av verksamhetsutövare?
Under de senaste åren har lagstiftning och tillsyn kring PFAS skärpts i Sverige och inom EU. Fler ämnen regleras, riktvärden för dricksvatten har sänkts, och diskussioner pågår om ett brett förbud mot stora delar av PFAS-gruppen.
För den som driver en verksamhet eller äger en fastighet innebär det här:
– högre krav på att kartlägga och förstå eventuella PFAS-källor
– ökade förväntningar från myndigheter, kunder och allmänhet
– potentiellt ansvar för historiska utsläpp
– behov av att kunna visa att man arbetar systematiskt med risker
Många upptäcker PFAS-föroreningar i samband med:
– markundersökningar vid fastighetsförsäljning
– detaljplaneändringar och exploatering
– tillståndsprövning eller tillsyn
– utredningar kring misstänkta förorenade områden, till exempel brandövningsplatser
En återkommande utmaning är att PFAS är så rörligt i grundvatten. En förorening som skapats för decennier sedan kan idag ha förflyttats hundratals meter, ibland betydligt längre. Därför räcker det sällan att bara provta på källan; man behöver förstå flöden, geologi och potentiella spridningsvägar för att göra en realistisk riskbedömning.
I praktiken handlar ansvarsfrågan ofta om att kunna svara på:
– Var kommer PFAS ifrån?
– Hur har ämnena spridits?
– Vilka människor eller verksamheter riskerar att påverkas?
– Vad är en rimlig åtgärdsnivå, både tekniskt och ekonomiskt?
Här blir strukturerade undersökningar och tydlig dokumentation avgörande. Bra underlag sparar både tid och pengar, och minskar risken för konflikt med myndigheter eller andra parter.
Undersökning, analys och åtgärd från osäkerhet till handlingsplan
När PFAS misstänks eller redan har påvisats behöver arbetet läggas upp steg för steg. Ett genomtänkt angreppssätt gör det möjligt att gå från osäkerhet till en konkret handlingsplan.
En typisk process kan bestå av:
1. Förstudie och historisk genomgång
Kartläggning av tidigare verksamheter, användning av brandskum, kemikalielistor, gamla ritningar och avfallsflöden. Syftet är att identifiera troliga källor och prioritera var provtagning gör störst nytta.
2. Provtagning i mark, grundvatten, ytvatten eller byggnadsmaterial
Urval av provpunkter baseras på spridningsvägar och geologi. Noggrann provtagning är avgörande, eftersom låga halter fortfarande kan vara relevanta ur både hälsosynpunkt och lagstiftningsperspektiv.
3. Laboratorieanalys och tolkning
Specialiserade laboratorier använder avancerade metoder för att hitta PFAS på mycket låga nivåer. Resultaten behöver sedan tolkas med hänsyn till gällande riktvärden, lokala förhållanden och osäkerheter i mätningarna.
4. Riskbedömning
Bedömning av kontaktvägar (dricksvatten, damm, livsmedel, direkt hudkontakt), exponerade grupper (barn, boende, arbetstagare) och långsiktiga effekter. Här vägs också in om området kan komma att ändra användning, till exempel från industri till bostäder.
5. Åtgärdsstrategi
I vissa fall är rening eller sanering nödvändig, till exempel vid dricksvattenbrunnar. I andra fall kan riskerna hanteras genom begränsad användning, skyddsåtgärder eller långsiktig övervakning. Viktigt är att välja lösningar som är tekniskt möjliga, ekonomiskt rimliga och hållbara över tid.
PFAS-området utvecklas snabbt. Nya forskningsrön, reningstekniker och regler kommer löpande. Därför behöver både verksamhetsutövare och fastighetsägare följa utvecklingen och regelbundet ompröva tidigare bedömningar, särskilt i känsliga miljöer.
För den som vill ha professionellt stöd i provtagning, analys och tolkning av PFAS-data kan det vara klokt att anlita en erfaren aktör inom miljöanalyser. Ett företag som arbetar dagligen med den här typen av frågor och avancerade laboratoriemetoder, som aklab.se, kan hjälpa till att ta fram ett underlag som håller för både teknisk granskning och myndighetsdialog.
















































